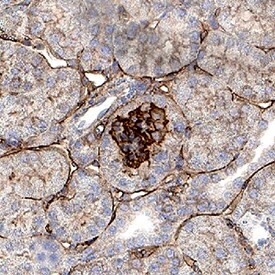
NPNT Antibody in Immunohistochemistry (Paraffin) (IHC (P))

Search
Invitrogen
NPNT Polyclonal Antibody
{{$productOrderCtrl.translations['antibody.pdp.commerceCard.promotion.promotions']}}
{{$productOrderCtrl.translations['antibody.pdp.commerceCard.promotion.viewpromo']}}
{{$productOrderCtrl.translations['antibody.pdp.commerceCard.promotion.promocode']}}: {{promo.promoCode}} {{promo.promoTitle}} {{promo.promoDescription}}. {{$productOrderCtrl.translations['antibody.pdp.commerceCard.promotion.learnmore']}}
图: 1 / 1
NPNT Antibody (PA5-47610) in IHC (P)

产品信息
PA5-47610
种属反应
已发表种属
宿主/亚型
分类
类型
抗原
偶联物
形式
浓度
规格
纯化类型
保存液
内含物
保存条件
运输条件
RRID
产品详细信息
Reconstitute at 0.2 mg/mL in sterile PBS.
靶标信息
Functional ligand of integrin alpha-8/beta-1 in kidney development. Regulates the expression of GDNF with integrin alpha-8/beta-1 which is essential for kidney development. May also play a role in the development and function of various tissues, regulating cell adhesion, spreading and survival through the binding of several integrins.
仅用于科研。不用于诊断过程。未经明确授权不得转售。
生物信息学
蛋白别名: Nephronectin; Preosteoblast EGF-like repeat protein with MAM domain
基因别名: 1110009H02Rik; AA682063; AI314031; Nctn; Neph1; Npnt; POEM
UniProt ID: (Mouse) Q91V88
Entrez Gene ID: (Mouse) 114249